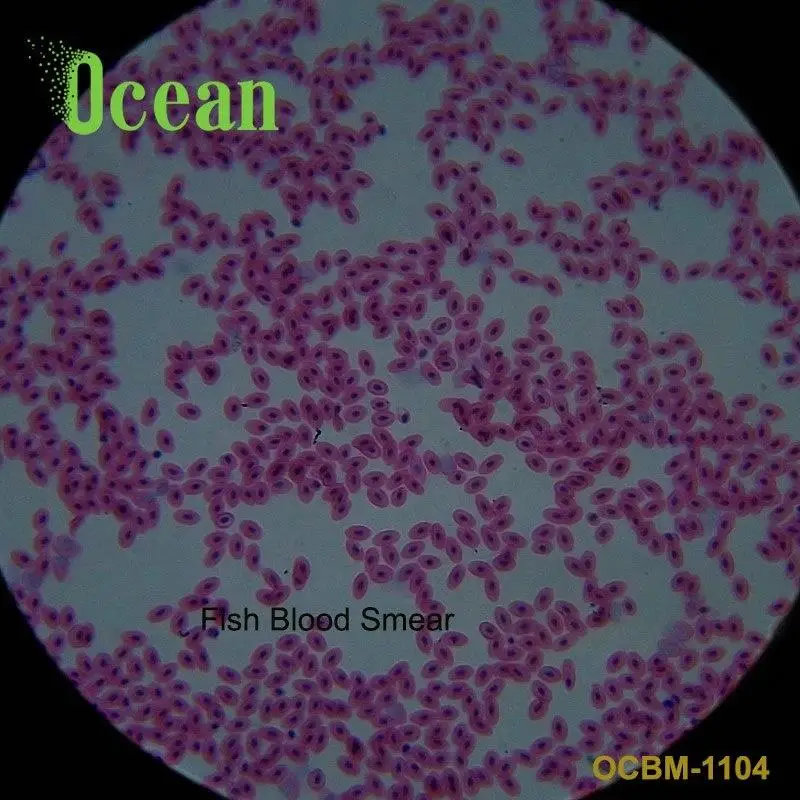
Fish Blood Smear zoology slides for medical research on prepared microscope slide

Other Educational Supplies

Safety biology glass slides plastic boxes from 100% factory
- Category:
- Supplier: Xinxiang,Vic,Science,&,Education,Co.,Ltd.
In Stock

Hot Sale High Quality Online Shop School Learning Apparatus Balance Weights
- Category:
- Supplier: Shengben,Teaching,AIDS(Zhejiang),Co.,Ltd
$4.00 - $4.50
In Stock

Electri Heating Wire Silicone Stainless Steel Metal Wire Cut Resistant For Heat
- Category:
- Supplier: Shengben,Teaching,AIDS(Zhejiang),Co.,Ltd
$0.35 - $0.45
In Stock

Basic Circuit Electromagnetic Learning Kit Physics-Assisted Magnetic control tester
- Category:
- Supplier: Shengben,Teaching,AIDS(Zhejiang),Co.,Ltd
$0.12 - $0.16
In Stock

skin zoology slides for medical research on prepared microscope slide
- Category:
- Supplier: Wuxi,Oceanedu,Import,And,Export,Co.,Ltd.
In Stock

Testis Section high quality lab histology microscope prepared slides
- Category:
- Supplier: Wuxi,Oceanedu,Import,And,Export,Co.,Ltd.
In Stock

Cinnaba Mineral Specimen Cinnabar Stone Mineral and Rocks Specimen
- Category:
- Supplier: Xinxiang,Vic,Science,&,Education,Co.,Ltd.
In Stock

Copper coil enameled coil physical experiment equipment for square coil induction current
- Category:
- Supplier: Shengben,Teaching,AIDS(Zhejiang),Co.,Ltd
$0.15 - $0.20
In Stock

High Quality Dial Spring Acrylic Tubular Spring Balance Weighing Scale
- Category:
- Supplier: Shengben,Teaching,AIDS(Zhejiang),Co.,Ltd
$0.40 - $0.50
In Stock

Low Price Gas Hi Voltage Amper Meter Voltmeter Ampere Dc Meter Multifunktion
- Category:
- Supplier: Taizhou,City,Funny,Many,Science,Instruments,Co.,Ltd.
$1.25 - $1.66
In Stock

physics lab equipment price list Lamp Socket Holder Pull Chain Lamp With Pen Holder
- Category:
- Supplier: Taizhou,City,Funny,Many,Science,Instruments,Co.,Ltd.
$0.10 - $0.13
In Stock

Весы с пружинным счетчиком, весы с пружинным балансиром плоского типа
- Category:
- Supplier: Taizhou,City,Funny,Many,Science,Instruments,Co.,Ltd.
0,40 $ - 0,50 $
In Stock

Модульный блок на батарейках magзагородного типа, интерактивный Магнитный умный игрушечный робот «сделай сам»
- Category:
- Supplier: Hangzhou,Zhiban,Education,Technology,Co.,Ltd,
11,99 $ - 14,99 $
In Stock

Factory low price wholesale oblique scientific instrument friction plate instrument with roller
- Category:
- Supplier: Shaoxing,Keqiao,Science,Instrument,Co.,Ltd.
$12.00 - $13.50
In Stock

Low-priced wholesale floating block test/up and down block water buoyancy teaching kit
- Category:
- Supplier: Shaoxing,Keqiao,Science,Instrument,Co.,Ltd.
$0.95 - $1.40
In Stock

Low price wholesale scientific instrument thermal conductivity meter metal thermal conductivity meter
- Category:
- Supplier: Shaoxing,Keqiao,Science,Instrument,Co.,Ltd.
$3.50 - $4.70
In Stock

Experimental Operation Three Light Sources Highlight Embedded Road Stud Driveway Markers
- Category:
- Supplier: Taizhou,City,Funny,Many,Science,Instruments,Co.,Ltd.
$1.20 - $1.55
In Stock